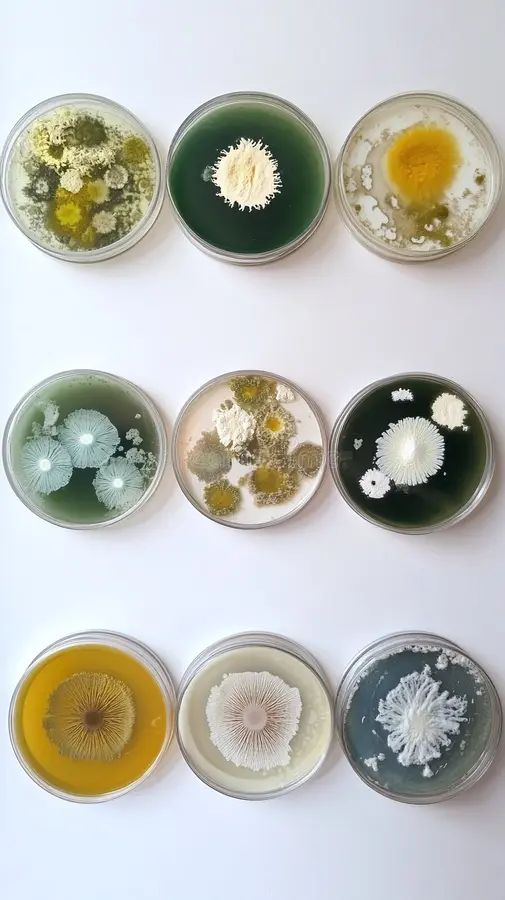

- Enseignant: Fethia HALFAOUI
- Enseignant: Sami TOUIL

- Enseignant: M.A - MAROK
This course introduces students to the fascinating world of fungi, exploring their taxonomy, morphology, physiology, and ecological roles. Students will examine the major fungal groups — from molds and yeasts to macrofungi — and investigate their reproductive strategies, both sexual and asexual. Special emphasis is placed on the relationships between fungi and other organisms, including mutualistic associations such as mycorrhizae and lichens, as well as pathogenic species affecting plants, animals, and humans.
Laboratory sessions provide hands-on experience in fungal isolation, culturing, and identification techniques.
Laboratory sessions provide hands-on experience in fungal isolation, culturing, and identification techniques.
- Enseignant: D. ALIM
- Enseignant: Rafika Mohammed Bouziane
- Enseignant: KHEIRA ADDOUCH
- Enseignant: Aicha TABOUCHE

This is the continuation of animal biosystematic material 1. The student will approach the rest of the kingdom of Animalia or Metazoa, containing other species of great importance in the field of agricultural sciences.
- Enseignant: Nadir BABA AISSA
- Enseignant: Sarra AYACHE

